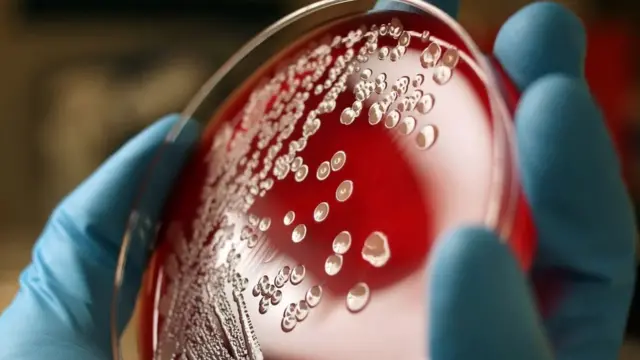
नखं, शास्त्र

तुमच्या नखांखाली दडलंय काय? नखं कुरतडायची सवय असेल तर हे नक्की वाचा

फोटो स्रोत, Getty Images
- Author, जेसन जी. गोल्डमन
- Role, बीबीसी फ्युचर
- वाचन वेळ: 4 मिनिटे
सर्व प्रकारच्या त्रासदायक जीवाणूंपासून बचाव करण्यासाठीची पहिली कृती म्हणजे हात धुणं. पण तुम्ही तुमची नखंही धुता का? बहुधा तसं करणंही तितकंच महत्त्वाचं आहे...
किटाणूंचा प्रसार रोखण्यासाठी हात धुणं हा सर्वोत्तम उपाय असल्याचं बहुधा तुम्हाला माहीत असेल. अनेक ठिकाणी अन्नसेवा उद्योगामध्ये संबंधित सेवा देणाऱ्यांचे हात स्वच्छ राहावेत यासाठी सार्वजनिक आरोग्यविषयक कायदेही आहेत. दुसऱ्या बाजूला, हात कितीही घासले तरी त्यावरचे सगळे जीवाणू कधीच जात नाहीत.
निर्जंतुकीकरण अशक्य असतं, त्यामुळे डॉक्टर व नर्स रुग्णांच्या संपर्कात येताना सर्वसाधारणतः हातमोजे घालून येतात.
कितीही वेळा हात धुतले तरी चाचणी केल्यावर जीवाणू सापडणारच, हे जवळपास शंभर वर्षांपूर्वी डॉक्टरांना कळून चुकलं होतं. पण हातांवर वस्तीला असणारे जीवाणू इतकी चिकाटी कुठून आणतात, याचं उत्तर मात्र संशोधकांना 1970च्या दशकारंभी सापडलं.

फोटो स्रोत, Getty Images
हाताची बोटं झाकलेली असतील, तर हात दीर्घ काल स्वच्छ राहतात. केवळ बोटांच्या टोकांवरच जीवाणू असतात असं नाही, तर नखांमध्येही जीवाणू असतात. नख म्हणजे केरॅटिनचं बारीक कवच असतं- गेंडा किंवा काळवीटाची शिंगही याच पदार्थापासून बनतात. तर, नखांमध्ये जीवाणूंचा संचय होतो.
नखांमध्ये नक्की कोण राहतंय, याचा शोध घ्यायला वैज्ञानिकांनी 1980च्या दशकात सुरुवात केली. पेनसिल्वानिया विद्यापीठातील त्वचाविज्ञान विभागमधील तीन संशोधकांनी 1988साली केलेल्या एका अभ्यासामध्ये 26 प्रौढ स्वयंसेवकांना त्यांचे हात धुण्यास सांगण्यात आले. त्याच विद्यापीठाच्या वैद्यकीय शिक्षणसंस्थेतील रुग्णांशी संपर्क न येणारे हे सर्व कर्मचारी होते.
नखांखालची जागा (याला subungual असंही म्हणतात) जीवाणू स्थायिक होण्याच्या दृष्टीने 'महत्त्वाची' असते. स्वयंसेवकांच्या हातांचे इतर भाग शेकडो ते हजारो जीवाणू राखून होते, तर प्रत्येक बोटाच्या निव्वळ subungual भागांमध्येच हजारो जीवाणू आढळले. हाताच्या उर्वरित भागांमध्ये ज्या प्रकारचे जीवाणू होते, तसेच नखांमध्ये होते, फक्त त्यांची संख्या खूप जास्त होती.
नखं आणि त्याखालील त्वचा यांच्यामध्ये जागा राहत असल्याने अतिसूक्ष्म स्वरूपातील या जीवाणूंना वाढण्यासाठी व पसरण्यासाठी परिपूर्ण वातावरण मिळत असावं, असाही एक तर्क संशोधक नमूद करतात. या जागेवर नखांमुळे व ओलाव्यामुळे जीवाणूंना प्रत्यक्ष शारीरिक संरक्षणही मिळतं. सातत्याने हात घासले तरी त्यांचं निर्जंतुकीकरण होत नाही, असे निष्कर्ष आधी निघालेले होते. त्यात आता या अभ्यासाच्या निष्कर्षांची भर पडली- "हात धुण्याच्या सर्वसामान्य पद्धतींमध्ये जे सूक्ष्मजीवविरोधी घटक वापरले जातात, त्यांची पोच नसते अशा जागांवर जीवाणू मोठ्या संख्येने असतात," असं अभ्यासकांनी लिहिलं.
आजारांचा प्रसार रोखण्यासाठी आपण ज्या सर्वोत्तम व सर्वांत सोप्या पद्धती वापरतो, त्यांचा काहीच परिणाम आपल्या नखांखालच्या जागेवर होत नाही.

फोटो स्रोत, Getty Images
परिचारिकांच्या नखांमध्ये राहणाऱ्या सूक्ष्मजीवांचं स्वरूप काय असतं, यावर छोट्या स्वरूपात का होईना पण सातत्याने संशोधन होतं आहे. केवळ नैसर्गिक नखांबाबतच हे संशोधन होतंय असं नव्हे, तर कृत्रिम नखं किंवा पॉलिश केलेली नखंही या संशोधनासाठी विचारात घेतली जात आहेत.
पेनसिल्वानिया विद्यापीठातील अभ्यासानंतर वर्षभराने, 1989 साली परिचारिकांच्या एका गटाने असं लिहिलं होतं की, "कृत्रिम नखांची सुरक्षितता व व्यवहार्यता याबाबतचे प्रश्न अजून अनुत्तरित असले, तरी आरोग्यसेवेचं काम करणारे अनेक जण या फॅशनला बळी पडले आहेत आणि आता ते कृत्रिम नखं लावत आहेत."
कृत्रिम नखं (नैसर्गिक नखांपेक्षा जास्त लांब असणारी ही नखं बहुतांश वेळा नेल-पॉलिशच्या आच्छादनाखाली असतात) लावलेल्या 56 परिचारिकांच्या बोटांच्या टोकांवर नैसर्गिक नखं असणाऱ्या 56 परिचारिकांच्या बोटांच्या तुलनेत अधिक जीवाणू आहेत का, हे संशोधकांना तपासायचं होतं. कृत्रिम नखं असलेल्यांच्या बाबतीत हात धुणं कमी-अधिक परिणामकारक ठरतं का, हेही त्यांना पाहायचं होतं.
तर, हात धुण्याच्या आधी आणि नंतर कृत्रिम नखं असलेल्या परिचारिकांच्या बोटांवर नैसर्गिक नखं असलेल्या परिचारिकांच्या तुलनेत अधिक जीवाणू होते. त्या रुग्णांकडे जीवाणूंचं प्रत्यक्ष हस्तांतरण करतच असतील, असा याचा अर्थ होत नाही, फक्त त्यांच्या बोटांच्या टोकांवर जास्त संख्येने जीवाणू असतात. पण अधिक जीवाणू असतील, तर रोगजंतूंच्या संक्रमणाची शक्यता वाढत तरी असावी, असं एक गृहितक आहे.
अशाच प्रकारचे अभ्यास 2000 व 2002 साली प्रकाशित झाले, त्यातही असेच निष्कर्ष नोंदवले होते. तोवर परिचारिकांसंदर्भात संशोधन करणाऱ्यांना असाही पुरावा सापडला होता की, कृत्रिम नखं आणि हात धुण्याच्या चुकीच्या पद्धती यांचाही संबंध असतो, त्यातून ही समस्या आणखी गंभीर होते. शिवाय, कृत्रिम नखांमुळे हातमोजे फाटण्याचीही शक्यता असते.
फोटो स्रोत, Getty Images
दुसऱ्या बाजूला, पॉलिश केलेली नैसर्गिक नखं वेगळा परिणाम साधतात. नेल-पॉलिशमधील बारीक चकत्या वा खाचांमध्ये जीवाणू वस्तीला येऊ शकतात, ही एक भीती असते. बाल्टिमोरमधील जॉन हॉप्किन्स रुग्णालयातील परिचारिकांनी 1993 साली रुग्णालयात काम करणाऱ्या, पण रुग्णसेवेशी संबंध नसलेल्या 26 प्रौढ कर्मचारी महिलांच्या नखांची तपासणी केली. या सर्व जणींची नखं बारीक कापलेली होती, आणि नेल-पॉलिश लावण्याआधी आणि लावल्यानंतर चार दिवसांनी त्यांची तपासणी करण्यात आली.
कृत्रिम नखांवरील नेल-पॉलिशने बोटाच्या टोकांवरील जीवाणूंची संख्या वाढल्याचं दिसत होतं, तसं काहीच नेल-पॉलिश लावलेल्या नैसर्गिक नखांच्या संदर्भात आढळलं नाही. "त्यामुळे नखं बारीक व स्वच्छ ठेवणं जास्त महत्त्वाचं असावं, नेल-पॉलिश लावा किंवा नका लावू," असा निष्कर्ष संशोधकांनी काढला. त्यानंतरच्या वर्षी केलेल्या दुसऱ्या एका अभ्यासातही अशाच प्रकारचे निष्कर्ष निघाले. चार दिवसांपूर्वी नेल-पॉलिश लावलेल्या नखांखाली जास्त जीवाणू होते, तर नव्याने नेल-पॉलिश लावलेली बोटं बहुतांशाने सुरक्षित होती.
दर वर्षी अतिसाराने सुमारे वीस लाख ते तीस लाख लोक मरण पावतात. साबणाने हात धुतले तर त्यातील दहा लाख लोक तरी वाचू शकतील, असं मानलं जातं. बहुधा ते खरंही असावं. पण हात धुण्यासोबतच आणखी एक गोष्ट परिणामकारक ठरू शकते: हात धुत असताना नखं व त्याखालील त्वचा या दरम्यानच्या जागेकडे विशेष लक्ष द्यावं आणि नखं बारीक ठेवावीव व स्वच्छ करावीत, म्हणजे तिथे जीवाणूंना कमीतकमी वाव मिळेल.
शिवाय, आता नखं कुरतडताना जरा सावध राहालच!
हे वाचलंत का?
या लेखात सोशल मीडियावरील वेबसाईट्सवरचा मजकुराचा समावेश आहे. कुठलाही मजकूर अपलोड करण्यापूर्वी आम्ही तुमची परवानगी विचारतो. कारण संबंधित वेबसाईट कुकीज तसंच अन्य तंत्रज्ञान वापरतं. तुम्ही स्वीकारण्यापूर्वी सोशल मीडिया वेबसाईट्सची कुकीज तसंच गोपनीयतेसंदर्भातील धोरण वाचू शकता. हा मजकूर पाहण्यासाठी 'स्वीकारा आणि पुढे सुरू ठेवा'.
YouTube पोस्ट समाप्त
(बीबीसी मराठीचे सर्व अपडेट्स मिळवण्यासाठी तुम्ही आम्हाला फेसबुक, इन्स्टाग्राम, यूट्यूब, ट्विटर वर फॉलो करू शकता.'बीबीसी विश्व' रोज संध्याकाळी 7 वाजता JioTV अॅप आणि यूट्यूबवर नक्की पाहा.)








